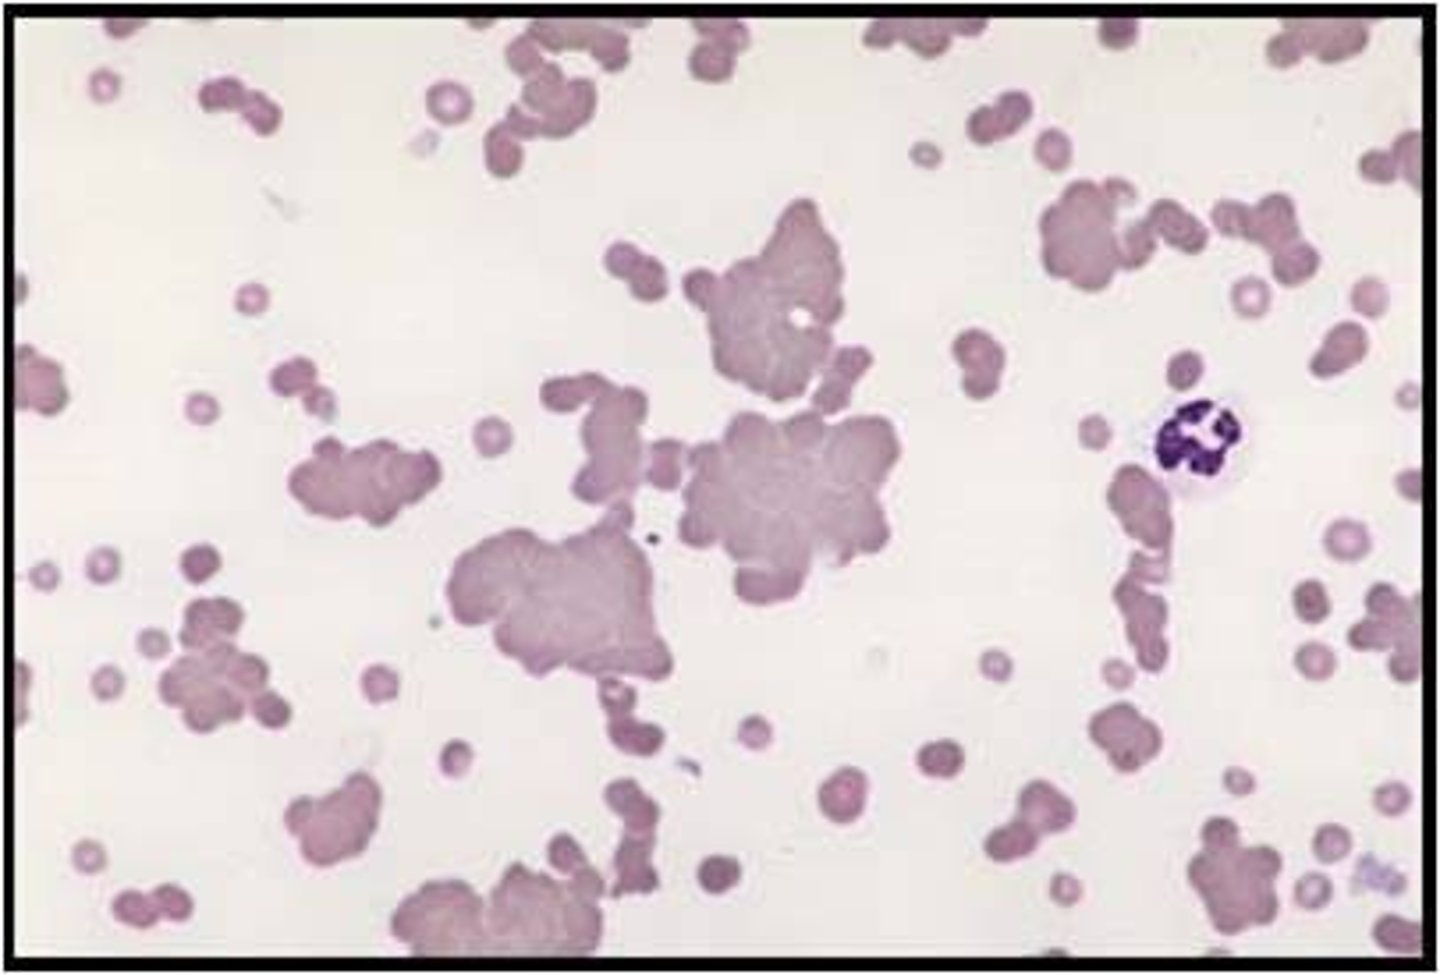
<p>clumping of red blood cells</p>

1/69
Looks like no tags are added yet.
Name | Mastery | Learn | Test | Matching | Spaced | Call with Kai |
|---|
No analytics yet
Send a link to your students to track their progress
left atrium
Chamber that receives oxygenated blood from the pulmonary veins and pumps it into systemic circulation.

left ventricle
Pumps oxygenated blood into the aorta

right atrium
the right upper chamber of the heart that receives blood from the venae cavae and coronary sinus

right ventricle
pumps deoxygenated blood to the lungs

vena cava
a large vein carrying deoxygenated blood into the heart

Aorta
The large arterial trunk that carries blood from the heart to be distributed by branch arteries through the body.

pulmonary veins
Deliver oxygen rich blood from the lungs to the left atrium

pulmonary artery
artery carrying oxygen-poor blood from the heart to the lungs

Arterioles
small vessels that receive blood from the arteries

Venules
small vessels that gather blood from the capillaries into the veins

Capillaries
Microscopic vessel through which exchanges take place between the blood and cells of the body

Plasma
Fluid portion of blood

Hematocrit
the ratio of the volume of red blood cells to the total volume of blood

whole blood
refers to the mixture of both plasma and formed elements

Platelets
blood clotting

red blood cells
Blood cells that carry oxygen from the lungs to the body cells.

While blood cells
leukocytes

bracheocephalic artery
supplies blood to the right arm and the head and neck

subclavian artery
Both a left and right, blood vessels that supply blood to the shoulders and upper limbs.

radial and ulnar arteries
arteries that run distally from the elbow and supply the hand

auxillary artery
artery in armpit area

Neutrophils
Most abundant white blood cell., The most abundant type of white blood cell. Phagocytic and tend to self-destruct as they destroy foreign invaders, limiting their life span to a few days.

Basophil
A circulating leukocyte that produces histamine.

Eosinophils
They're part of your body's defense system against allergens and help protect your body from fungal and parasitic infections.

Lymphocytes
The two types of white blood cells that are part of the body's immune system: B lymphocytes form in the bone marrow and release antibodies that fight bacterial infections; T lymphocytes form in the thymus and other lymphatic tissue and attack cancer cells, viruses, and foreign substances.

Monocytes
An agranular leukocyte that is able to migrate into tissues and transform into a macrophage.

T cells
Cells created in the thymus that produce substances that attack infected cells in the body.

B cells
Cells manufactured in the bone marrow that create antibodies for isolating and destroying invading bacteria and viruses.

Erythropoietin
A hormone produced and released by the kidney that stimulates the production of red blood cells by the bone marrow.

blood typing
The blood of one person is different from another's due to the presence of antigens on the surface of the erythrocytes. The major method of typing blood is the ABO system and includes types A, B, O, and AB. The other major method of typing blood is the Rh factor, consisting of the two types, Rh+ and Rh-.

Agglutination
clumping of red blood cells
cardiac output
The volume of blood ejected from the left side of the heart in one minute.

SA node
pacemaker of the heart, begins conduction

AV node
relays electrical impulses from atria into ventricles

Perkinje fibers
End of the conduction system; sends impulses through the ventricles, causing them to contract

ECG
electrocardiogram

PQRS wave

stroke volume
The amount of blood ejected from the heart in one contraction.

Systole
contraction phase of the heartbeat

Diastole
relaxation phase of the heartbeat

bicuspid valve
valve between the left atrium and the left ventricle.

tricuspid valve
valve between the right atrium and the right ventricle

pulmonary semilunar valve
heart valve opening from the right ventricle to the pulmonary artery

aortic semilunar valve
located between the left ventricle and the aorta

Rh factor
Refers to the presence or absence of the Rh antigen on red blood cells.

upper respiratory tract
consists of the nose, mouth, pharynx, epiglottis, larynx, and trachea

lower respiratory tract
larynx, trachea, bronchi, lungs

Pharynx
throat; passageway for food to the esophagus and air to the larynx

Larynx
voice box; passageway for air moving from pharynx to trachea; contains vocal cords

Trachea
Allows air to pass to and from lungs

Bronchi
The passages that direct air into the lungs

Bronchioles
Airways in the lungs that lead from the bronchi to the alveoli.

Alveoli
tiny sacs of lung tissue specialized for the movement of gases between air and blood

Lungs
two spongy organs, located in the thoracic cavity enclosed by the diaphragm and rib cage, responsible for respiration

gas exchange
Breathing, transport of gases, and exchange of gases with tissue cells; Provides O2 for cellular respiration and removes its waste product, CO2

respiratory rate
number of breaths per minute

Asthma
A chronic allergic disorder characterized by episodes of severe breathing difficulty, coughing, and wheezing.

Bronchodialator Drugs
they "dilate the bronchi and bronchioles" thereby opening the airway; helps to decrease wheezing

Diaphragm
Large, flat muscle at the bottom of the chest cavity that helps with breathing

external intercostals
elevates ribs during inspiration

Ventilation
movement of air in and out of the lungs
intrapulmonary pressure
pressure within the lungs

Inhalation
the act of taking in air as the diaphragm contracts and pulls downward

Exhalation
The passive part of the breathing process in which the diaphragm and the intercostal muscles relax, forcing air out of the lungs.

intrapleural pressure
pressure in the pleural cavity surrounding the lungs

negative pressure breathing
A breathing system in which air is pulled into the lungs when the lung volume is expanded.

Emphysema
a condition in which the air sacs of the lungs are damaged and enlarged, causing breathlessness.

Hemaglobin saturation at altitude
decrease
hemoglobin saturation
The percentage of heme units in a hemoglobin molecule that contain bound oxygen

Anemia
A condition in which the blood is deficient in red blood cells, in hemoglobin, or in total volume.